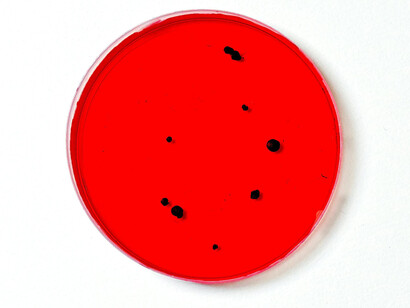
Close up of a medical sample

The human body is an ecosystem that contains not just eukaryotic cells (sometimes just called human cells), but also bacteria and archaea (prokaryotic cells), as well as viruses, fungi, yeasts and protozoa1-2. In fact, the bacteria in our gut contain far more protein-coding genes (millions) than the ‘human’ cells that have a little over 20,000 protein-coding genes, located in two pairs of 23 chromosomes. The gut microbiome extends from the esophagus to the lower intestines. These enteric bacteria interact with the central, autonomic and peripheral nervous systems as part of the microbiota-gut-brain axis. Moreover, there are also neurons in the gut or enteric system. This is called the enteric nervous system (ENS).
The ENS is a separate branch of the autonomic nervous system. The ENS exists throughout the length of the gastrointestinal tract (GIT). The GIT is densely innervated by a network of 200–600 million neurons. These neurons innervate all regions of the GIT. The ENS influences the physiology and function of the GIT, while communicating with the central nervous system (CNS) by both parasympathetic and sympathetic vagal pathways.
Sometimes, the ENS is called our second brain because it contains many types of neurons and glial cells that are linked in complex circuitry, similar to the brain in our skull. The ENS regulates many systems in the bowel while coordinating digestive and defensive functions in the gut. Defects in its development in utero and/or subsequent damage after birth can cause vomiting, abdominal pain, constipation, irritable bowel syndrome (IBS), Hirschsprung disease, growth failure, and early death. At the same time, the ENS produces new neurons in postnatal and adult lives, thus affecting our health and behavior throughout life.
Many of the enteric neurons relay sensory information in the gut to the CNS. Enteric glial cells are also important in the ENS. Like glial cells in the CNS, enteric glial cells were originally thought to have merely supportive roles, but are now known to be actively involved in the ENS. They link enteric nerves, enteroendocrine cells, immune cells, and epithelial cells. Enteric glial cells also link the nervous and immune systems, while playing important roles in gastrointestinal disorders.
Interactions go both ways in a bidirectional network of communication that connects the ENS with the CNS and the rest of the neuroendocrine nervous system. This network connects the emotional and cognitive centers of the brain with intestinal functions through the neural, endocrine and immune systems. Our gut microbiome affects our behavior, health, intelligence and emotions. The composition of bacteria in our gut is not hard-wired. It depends on what our mothers eat when we are in utero and what we eat after we are born, as well as our exposure to antibiotics. Our intelligence and behavior are subject to change through training, education, exposure to environmental toxins and even our diet (which affects our gut microbiome).
Dysbiosis in the gut microbiota-gut-brain axis plays important roles in aberrant social behavior as well as the etiology of several neurodegenerative diseases, including anxiety, depression, autism and Parkinson’s disease. Neurodegenerative diseases can certainly affect one’s intelligence and emotions, which are not hard-wired by our human genes. The gut microbiome and ENS also play important roles in maintaining homeostasis and the production of energy as well as influencing obesity. As a result, the ENS is also an important factor in diabetes, inflammatory diseases, colorectal cancer, chronic kidney disease, atherosclerosis and heart disease. The human gut microbiota also produces melatonin, which helps cause the gut to have circadian rhythmicity (the 24-hour cycle that affects sleep and many physiological processes).
The gut microbiota and ENS can be thought of as an entero-endocrine organ that has many more cells and protein-coding DNA than the rest of the human body. The GIT is a major hub in the communication network in the human body. It contains the highest concentration of immune cells in the body. It is a network consisting of 200-600 million neurons and trillions of viruses, Bacteria, Archaea and Eukarya that make up the human gut microbiota. The gut microbiome helps to regulate intestinal function and interacts with the rest of the body to maintain good health. The gut microbiota is like a conductor of communication between the immune and neuroendocrine network. That is, the microbiota produces and secretes hormones, responds to hormones secreted by human eukaryotic cells and regulates their expression. Many of the biosynthetic pathways that produce neuroendocrine hormones are found in bacteria as well as human eukaryotic cells.
So, the gut microbiota produces and responds to neurohormones that are secreted in response to a neuronal input. Microbiota can modulate behavior through neurohormones such as serotonin, dopamine and norepinephrine. At the same time, these neurohormones can alter growth, motility, biofilm formation and/or virulence of bacteria. Serotonin may be a major neurotransmitter in the brain, but 90 % of it is located in the intestines. It is a key signaling molecule in both the gut and the brain. Moreover, the microbiota, hormones and the human Eukaryotic cells all work together to help maintain a healthy immune system.
Diet, exercise, mood, overall health, stress and gender can change the concentrations of hormones that can affect the gut microbiome. The opposite also occurs. A healthy gut microbiota can help keep a person calm because bacteria affect the concentrations of stress hormones (corticosterone and adrenocorticotropic hormone, or ACTH). On the other hand, dysbiosis in the gut microbiome can contribute to autoimmune diseases, including type-1 diabetes. This inter-kingdom form of communication has been called microbial endocrinology.
For example, the stress-mediated excretion of neurohormones can alter the expression of genes in pathogenic bacteria in the gut. Hormones and neurotransmitters affect many aspects of behavior, which is not simply hard-wired in the brain that is in one’s skull. Our health and behavior also depend in part on the gut microbiome – our second brain. As a result, our behavior and mental skills are influenced by our lifestyle, diet and exposure to antibiotics. They are not hard-wired by the genes we inherit upon conception.
However, when many authors write about the number of different types of human cells they are referring to the human eukaryotic cells3-4. As recent as 2023, the number of human cell types in adults and children was estimated to be slightly over 400, but at least one source estimated that there are about 1200 cell groups5. It was also estimated that there are a total of about 36 trillion cells in a 70 kg male, 28 trillion in a 60 kg female and 17 trillion in a 10-year old child who weighs 32 kg. There is even a human cell atlas, which is an international effort to build a comprehensive reference atlas of cells across all organs, tissues, and systems of the human body6. Until recently, cell types were identified by morphology and other factors.
When analyzing such groups, it was necessary to obtain many cells. This forced researchers to measure the average properties of such cells. The average activities and amounts of many proteins were determined. This was based, in part due to the central dogma of molecular biology – DNA codes for RNA, which codes for proteins, which do the important work in cells. That is, information flows from DNA to RNA to proteins. DNA was thought to be the blueprint of life.
However, we have realized for many decades that the central dogma is wrong. There is a huge layer of control that is above genetics. It is called epigenetics. That is, our cells must be able to respond appropriately to the constantly changing needs of the organism as it interacts with the environment. Genes must be turned on and off at appropriate times from conception, through gestation, development and all the cycles of life. So, the transcription of genes into RNA is controlled by epigenetic modifications. Things like sugars, lipids, phosphates, methyl and acetyl groups can be added to DNA and proteins to control transcription. Also, epigenetic modifications can control the translation of messenger RNA into proteins.
There are many other types of RNA, such as micro RNA (miRNA) that helps to regulate translation. Still, only the average of types and amounts of epigenetic changes could be measured until recently. Technological advances have enabled scientists to look closely at individual cells. We can quantify the amount and types of RNA and protein molecules that an individual cell produces. Moreover, we can use very sensitive methods of detection that allow us to quantify many more proteins and RNA molecules, including those that are present at low concentrations. Many of the key proteins and RNA that control metabolism are present at low concentrations. So, new technologies are letting us see more and identify small differences. One such technique is single cell liquid chromatography, coupled with mass spectrometry (scLC-MS)7-9.
That is, a single cell is taken and processed to produce an aqueous solution that contains proteins and RNA. The aqueous solution is injected onto a column that is packed with material that enables the many types of proteins and RNA to be separated from each other. As each peptide, protein and RNA molecule is washed off the column, it enters a mass spectrometer, which measured their masses and relative abundance. This enables the analyst to measure the proteins (the proteome), plus the RNA that is transcribed from DNA (the transcriptome). This includes the ability to distinguish between different forms of a protein (such as amyloid and tau in the brain), including protein aggregates formed by misfolded proteins such as the β-amyloid which forms plaques in the brains of patients with Alzheimer’s disease. Protein aggregates can cause cells to age and become senescent. To help prevent this, young, healthy cells use a class of proteins called molecular chaperones. These proteins preserve or change the three-dimensional conformation of proteins that function properly.
One of them, cyclophilin A, interacts with intrinsically disordered proteins while they are being made and ensures they keep the appropriate conformations and are maintained at sufficient levels for proper health. This is especially important for hematopoietic stem cells (HSCs), which must survive for a very long time. HSCs form blood cells. They make rapidly dividing progenitor cells, which in turn make hundreds of billions of cells. This meets the daily demand for red blood cells (which carry oxygen), as well as white blood cells (that fight infections and diseases) and platelets that form blood clots.
So, scLC-MS was used to analyze human brain cells and produce detailed cellular maps that are more detailed than before10-11. It can detect and quantify thousands of proteins, proteoforms, and post translational modifications in single cells. More than 3000 different kinds of brain cells were identified by a consortium of researchers. It was part of a continuing effort to understand the human brain and its nature. It was brought together and is funded by the National Institutes of Health’s Brain Research Through Advancing Innovative Neurotechnologies® (BRAIN) Initiative.
Scientists from around the world studied the cellular makeup of the human brain and those of other primates. They studied the detailed organization of the human brain at an unprecedented detail. Mammalian brains have billions of neurons and glial cells that have highly complex behaviors. These cells are organized into several major functional regions with distinct developmental origins. Each brain area contains a specific complement of cell types, including neurons and glial cells. The brainstem has a very diverse set of neurons that may support innate behaviors.
They looked at the variability in brain cell types between individual people. They found that found we all have the same types of brain cells, but their proportions vary substantially from person to person. They also compared human brain cell types with those of chimpanzees and gorillas (our closest relatives). They found that we share the same basic brain cell type architecture with our close evolutionary cousins. However, there are changes in the genes used by those conserved cell types. Importantly, many genes involved in connections between neurons and the formation of circuits in the brain are different in humans and these primates. They also compared the cells found in different regions of the cerebral cortex, which controls many of our most advanced cognitive functions. They explored the properties of inhibitory neurons in the human neocortex, including their electrical properties and their complex 3D shapes in addition to the genes that are transcribed.
The information obtained helps us understand not only how healthy brains function, but also find the causes of neurodegenerative diseases and disorders. This could ultimately lead to better treatments and even cures. The next phase of research will build much more comprehensive atlases of human and other primate brains through the BRAIN Initiative’s Cell Atlas Network, or BICAN.
In the meantime, other scientists recently looked at the part of the brain called the caudal nucleus of the solitary tract (cNST) 12. It is a part of the brainstem region that helps the brain communicate with the rest of the body. The cNST is the primary target of the vagus nerve, which links the brain in our head with the brain in our gut (the enteric nervous system). They identified specific groups of neurons within the cNST and the vagus nerve that help detect and control inflammation. The cNST acts like a thermostat for the immune system, helping to maintain a balanced response to inflammation. The researchers found specific neurons in the vagus nerve and the cNST that detect and control inflammation. These neurons respond to different immune signals, including pro-inflammatory and anti-inflammatory cytokines.This could revolutionize the way we treat a variety of immune-related diseases.
Conditions such as rheumatoid arthritis, multiple sclerosis, and inflammatory bowel disease, which are currently managed but not cured, might benefit from therapies that target the brain’s control over inflammation. This discovery could also lead to new treatments for acute inflammatory conditions, such as the severe immune reactions seen in some viral infections, including COVID-19. The potential to modulate the immune system through the brain opens up a new realm of possibilities in medical treatment, offering hope for better management and perhaps even cures for chronic and acute inflammatory diseases.
Single cell analysis can also give important information about the immune system, which must be kept in balance for good health. Some activity is needed to fight off infections and heal wounds. However, an overactive immune system can cause autoimmune diseases, such as irritable bowel syndrome (IBS). So, researchers used single-cell RNA sequencing to study the effects of interleukin-23 (IL-23) on different types of immune cells in the healthy intestine. It interacts with group 3 innate lymphoid cells (ILC3s), a family of immune cells that are a first line of defense in mucosal tissues such as the intestines and lungs. In response, ILC3s increase the biological activities of beneficial gut microbiota and of cytotoxic T-lymphocyte associated protein number 4 (CTLA-4).
It is a regulatory factor that prevents the immune system from attacking the body. This interaction critically balances the pro-inflammatory effects of IL-23 to maintain gut health, but is impaired in IBS. So, ILC3s is a critical link between proinflammatory effects of IL-23 in the intestines. Hopefully, further research on this pathway will help us fight cancer and alleviate a serious side effect of cancer immunotherapy.
Our immune system is also very important in aging. Proper balance can slow down biological aging. Unbalanced immune systems can accelerate aging. They do this through epigenetic changes which can be used to estimate biological age. A recent study described how immune cell profiles relate to estimates of biological age based on epigenetic clocks13. They calculated an Intrinsic Epigenetic Age Acceleration (IEAA) level that provided a better understanding of the aging process at a cellular level. This improved our understanding of epigenetic clocks by showing how various immune cell subsets contribute to epigenetic aging.
So, the epigenome is at least as important as the genome (the DNA in our 23 pairs of human chromosomes). There are many types of –omics, including epigenomics, transcriptomics, proteomics, lipidomics, metabolomics and glycomics, as well as exposomics. They are the collections of all the epigenetic modifications, transcription products, proteins, lipids, metabolites and glycans (carbohydrates) in a cell or organism, as well as the effects of exposure to environmental chemicals.
Single-cell multi-omics technologies are revolutionizing cancer research14. It is now possible to discover the heterogeneity within tumors and understand the unique molecular characteristics of different populations of cells. We can identify rare subpopulations of cells that are influential in tumor growth, metastasis, and resistance to therapy. We are also learning more about the immune response to various therapies. This includes immune checkpoint blockade, chemotherapy, and cell therapy. We are also learning much more about the tumor microenvironment and its impact on patient prognosis and response to treatment. This interdisciplinary approach aims to describe the intricate interplay between genomics, epigenomics and other -omics. This interdisciplinary approach is holistic. It is helping us understand cellular development, pathogenesis, and other fundamental biological processes. The progress in next-generation sequencing and mass spectrometry is teaching us how the transcriptome, methylome, proteome, histone post-translational modifications, and the microbiome influence health and diseases.
For example, an atlas of epithelial cell states and plasticity in lung adenocarcinoma was produced recently15. It helps us understand the cellular processes involved in early lung adenocarcinoma (LUAD). They studied 246,102 single epithelial cells from 16 early-stage LUADs and 47 matched normal lung samples. Epithelial cells that had a critical mutation in a gene called KRAS were shown to be precursors of cancer cells in the lungs. This provided new insights into epithelial cell states at the root of LUAD development. Some of these states could have potential targets to prevent or cure LUAD.
In another study, the heterogeneity of pancreatic cancer cells was studied using single cell RNA analysis and spatial transcriptomics16. Pancreatic ductal adenocarcinoma (PDAC) is a highly lethal form of cancer. It has a heterogeneous genetic landscape and an immunosuppressive tumor microenvironment. Researchers looked at both malignant and host cell types. They learned more about the heterogeneity and plasticity of PDAC during therapy.
So, we will continue to study the many types of cells in the human body. This includes bacterial cells in our gut, healthy human eukaryotic cells and the large diversity of cancer cells.
Notes
1 Smith, R.E. Dietary fiber, the gut microbiome and health, Meer.
2 Smith, R.E. Our second brain, Meer.
3 Murugesu, J.A. We now know how many cells there are in the human body, New Scientist.
4 Mostafa, H.K.K. Different cells of the human body: Categories and morphological characters, Journal of Microscopy and Ultrastructure.
5 Hatton, I.A., et al. The human cell count and size distribution, Proceedings of the National Academy of Sciences.
6 Human Cell Atlas, 2024.
7 Single cell proteomics, ThermoFisher Scientific.
8 Ye, X. et al. Combination of automated sample preparation and micro-flow LC–MS for high-throughput plasma proteomics, Clinical Proteomics.
9 Zheng, R. et al. A high-sensitivity low-nanoflow LC-MS configuration for high-throughput sample-limited proteomics, Analytical Chemistry.
10 Tompa, R. What makes us human? Detailed cellular maps of the entire human brain reveal clues, Allen Institute.
11 Siletti, K. et al. Transcriptomic diversity of cell types across the adult human brain, Science.
12 Jin, H. et al. A body–brain circuit that regulates body inflammatory responses, Nature.
13 Zhang, Z. et al. Deciphering the role of immune cell composition in epigenetic age acceleration: Insights from cell‐type deconvolution applied to human blood epigenetic clocks, Aging Cell.
14 Liang, A. et al. Advancements and applications of single-cell multi-omics techniques in cancer research: Unveiling heterogeneity and paving the way for precision therapeutics, Biochemistry and Biophysics Reports.
15 Han, G. et al. An atlas of epithelial cell states and plasticity in lung adenocarcinoma, Nature.
16 Bärthel, Stefanie, et al. Single-cell profiling to explore pancreatic cancer heterogeneity, plasticity and response to therapy, Nature Cancer.